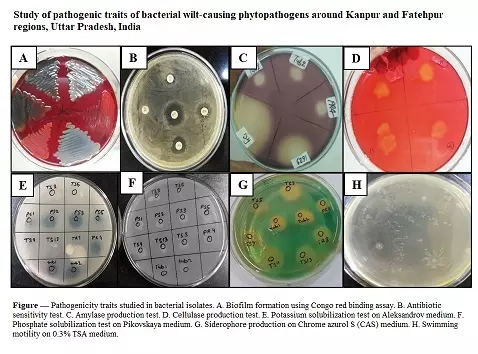
Graphical Abstract

Journal of Applied
Biology & Biotechnology
ISSN Print: 2455-7005, ISSN Online: 2347-212X
Frequency: Bimonthly
Indexing: Scopus, Web of Science and many more
Editor in Chief : Dr. Ajar Nath Yadav